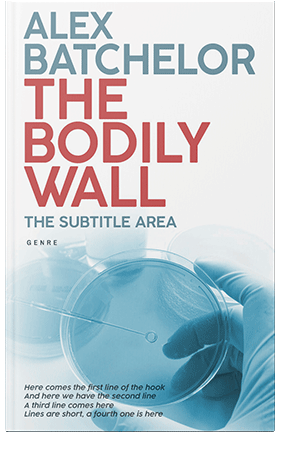
Pre Made Book Cover Half Baked

Analysis Book Covers

Tower Gray #34677
-10%$99.00$89.00

Gable Green #34678
-10%$99.00$89.00

Heavy Metal #29932
$99.00

Vulcan #28514
-10%$99.00$89.00

Alto #29417
$99.00

Bunker #15869
$99.00

Cloud Burst #28516
$99.00

Big Stone #30366
$99.00

Zeus #29095
$99.00

Mischka #17742
$99.00

Ebony #21437
$99.00

Soft Peach #17733
$99.00

Malibu #34690
-10%$99.00$89.00

Ebony Clay #32224
-10%$99.00$89.00

Vulcan #28515
-10%$99.00$89.00

Opal #28519
-10%$99.00$89.00

Link Water #28481
-10%$99.00$89.00

Dune #15862
$99.00

Firefly #32491
$99.00

Hampton #31542
$99.00

Tower Gray #36276
$99.00

Big Stone #31577
$99.00

Buttercup #33919
$99.00

Satin Linen #15666
$99.00

Wattle #29933
$99.00

Merlin #15324
$99.00
Half Baked #6595
$99.00

Mirage #29421
$99.00

Lochmara #11214
$99.00

Pomegranate #29507
$99.00

Genoa #11212
$99.00

Black Pearl #30365
$99.00

Quill Gray #1821
-51%$99.00$49.00

Bali Hai #0176
-51%$99.00$49.00

Ebony Clay #3563
-30%$99.00$69.00

Fiord #15842
$99.00

Hippie Blue #2788
$99.00

Silver Sand #2340
-30%$99.00$69.00

Cloud #29074
$99.00

Cello #6807
$99.00

Sunglo #1924
-51%$99.00$49.00

Glacier #1807
-30%$99.00$69.00















